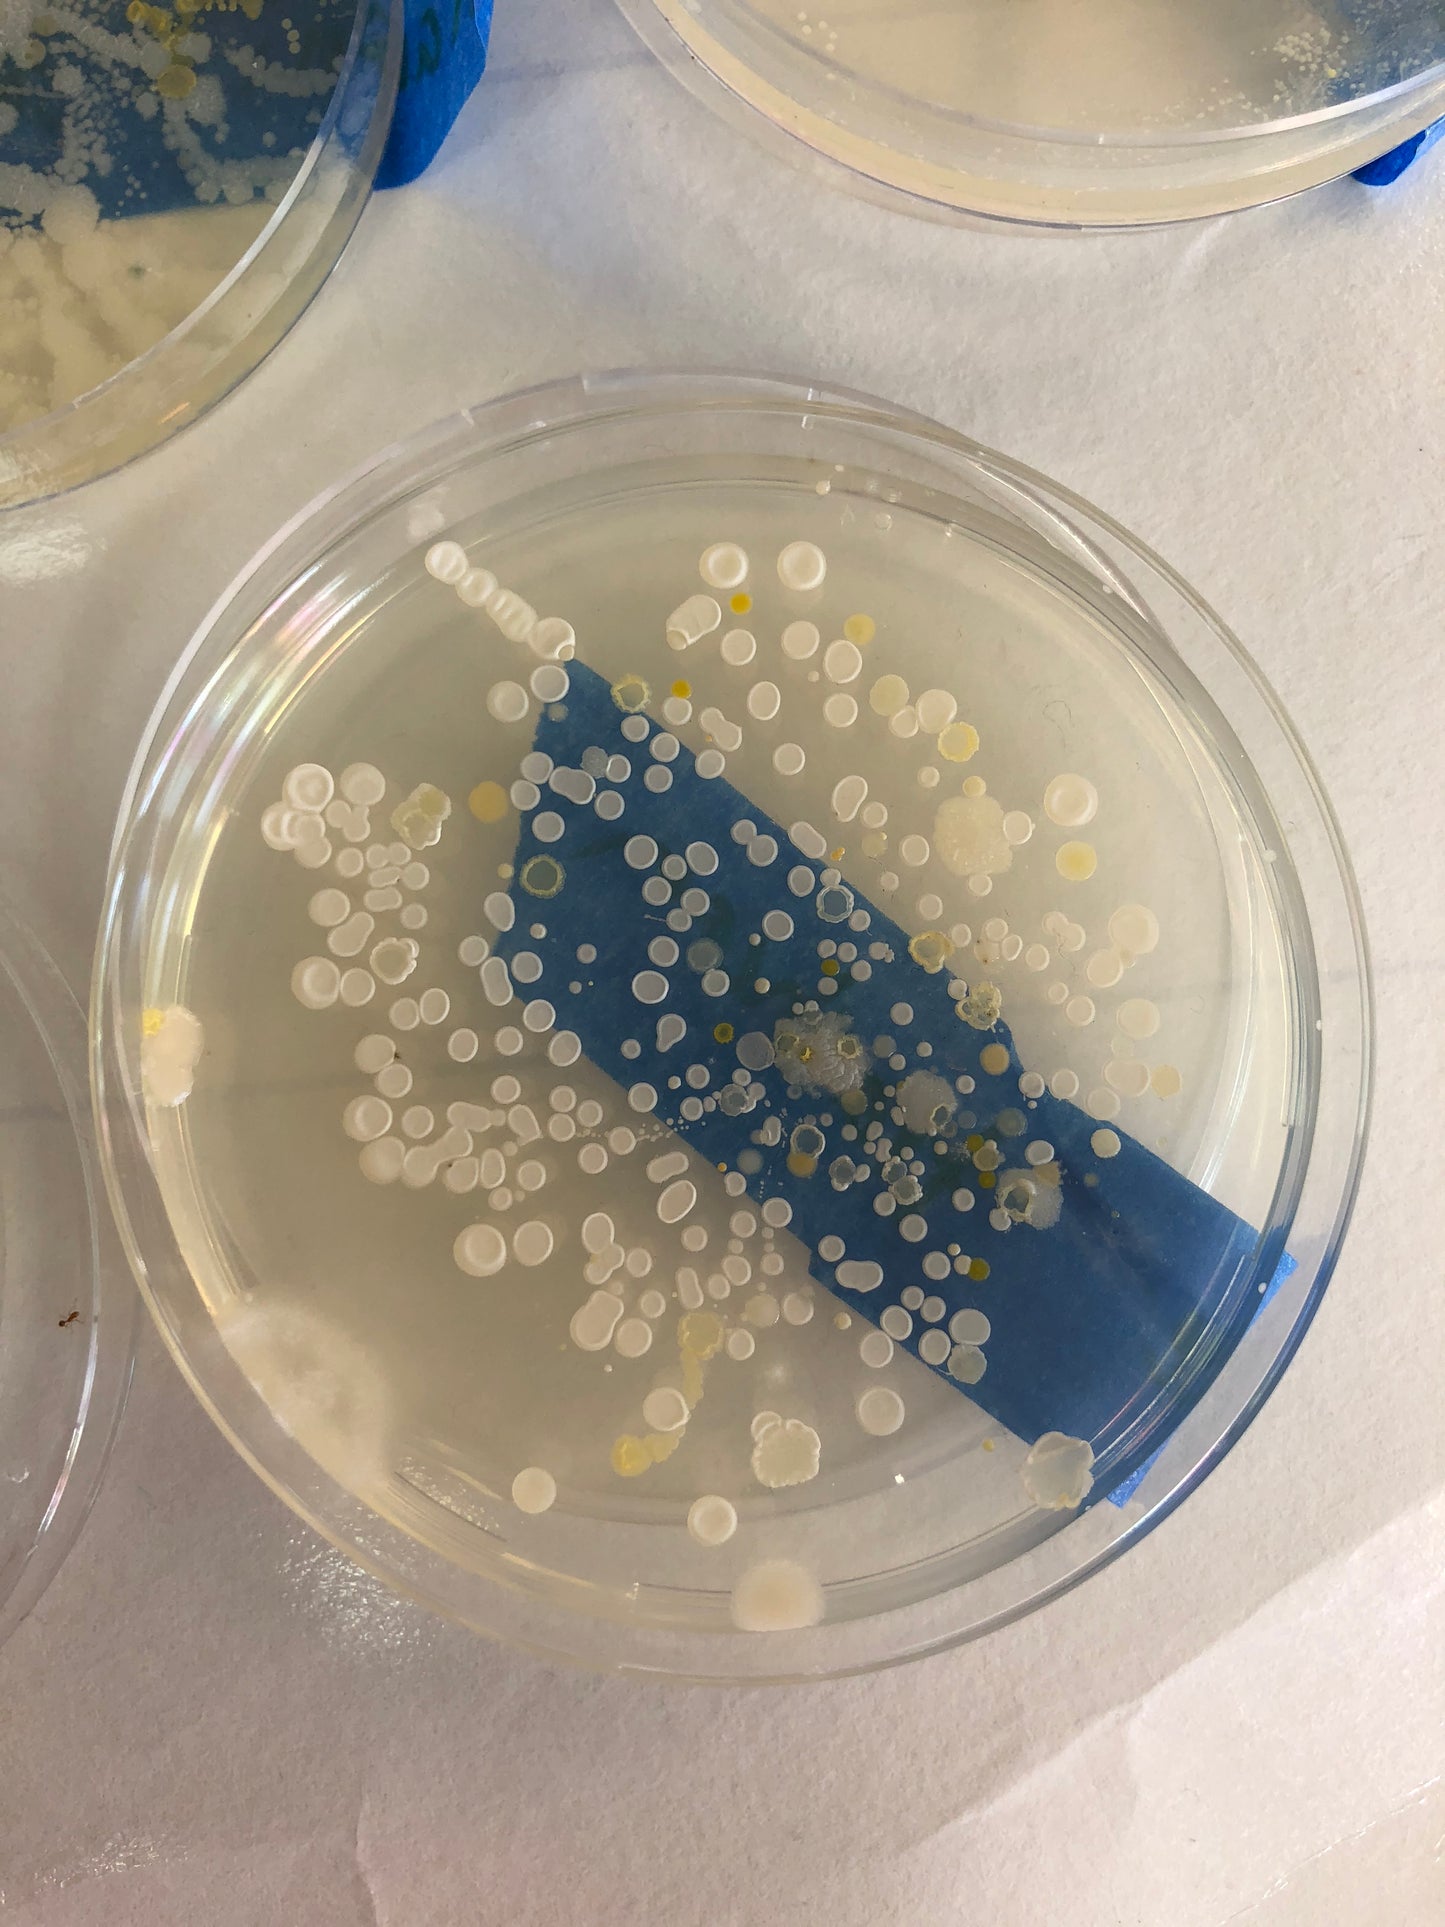

Student Scientists In The Classroom: Set 2 - 11 Hands-On Science Experiments
These 11 simple, hands-on science experiments will bring science fun into your classroom. Students will learn the scientific method as they conduct hands-on science experiments. They will learn to follow directions, safely conduct experiments, and record their observations. They will also learn science vocabulary.
Each experiment is designed for students to do a majority of the experiment. Most of the experiments require teacher preparations ahead of time.
Included with each experiment are two recording sheets. One sheet asks students to draw their hypotheses and observations. The second is for students to write their responses.
Includes:
- Exploding Milk
- Glow In The Dark Flowers
- Sparkling Gems
- Classroom Germs
- Monkey Slime
- Make Your Own Bouncy Balls
- Fairy Potion
- Pirate Slime
- Bubble Painting
- Unicorn Slime
- Fizzy Ice
- Vocabulary Cards
Don't Miss Our Other Student Scientists Creations:
Student Scientists In The Classroom
Student Scientists Holiday Edition
___________________________________________________________________________
Please check out our website to read our blog, download freebies & handouts in the Resource Center, see where Mr. Greg will be making appearances in the Events tab, and more. Visit our website here: The Kindergarten Smorgasboard
Thank you!
Greg & Jason Warren
kindersmorgie@gmail.com

Student Scientists In The Classroom: Set 2 - 11 Hands-On Science Experiments